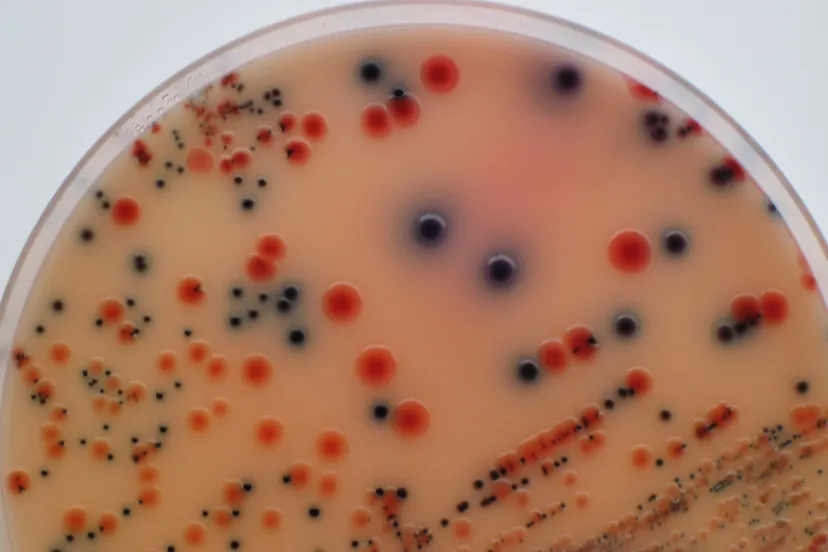
bacterie

Veilig Verkeer Nederland en de Vervoerregio Amsterdam stellen weer gratis actiepakketten beschikbaar voor buurt en, vereniging en, hobbyclubs, bedrijven of scholen om fietsverlichting te controleren en waar nodig te repareren.
Nadat de klok i n de nacht van zaterdag 27 op zondag 28 oktober verzet wordt en het in de ochtend- en avondspits weer donker is, is het van levensbelang dat fietsverlichting werkt. Met h et actiepakket Fietsverlichting is heel gemakkelijk de fietsverlichting van fietsers in de eigen omgeving te controleren . Er zitten handige checklists voor fietsers in , een handleiding voor de controles en een leuke gadget om fietsers te belonen die hun verlichting goed voor elkaar hebben: een opvallende reflecterende sleutelhanger in de vorm van een fiets.
De grootte van het pakket is afhankelijk van het aantal fietsen dat
gecontroleerd gaat worden. Dat moet worden aangegeven bij de aanmelding. Het pakket is hier aan te vragen. Goed om te weten: